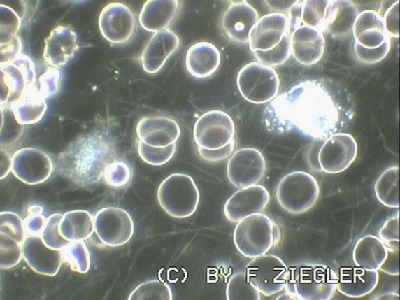

Die Ernährung leistet einen wesentlichen Beitrag zur Gesundheit, oder eben auch zur Krankheit. Die Ernährung leistet einen wesentlichen Beitrag zur Gesundheit, oder eben auch zur Krankheit.
Die Weltgesundheitsorganisation hat in Kooperation mit vielen Gesundheitsministerien und Gesundheitsinstituten inzwischen wissenschaftlich belegt, was eigentlich jeder Mensch weiss:
Obst und Gemüse ist gesund.
Eine im Wesentlichen auf Obst und Gemüse basierende Ernährung schützt nachhaltig von den "Zivilisationskrankheiten" Krebs, Diabetes, Arthrose usw.
In Obst und Gemüse sind die Wirkstoffe enthalten, die unsere Zellen benötigen. Und es sind weit mehr als die viel zu hoch eingeschätzten Vitamine: es sind die Sekundären Pflanzenstoffe (SPS), die Farbe, Geruch und Geschmack ausmachen in Verbindung mit einer Vielzahl von Enzymen, die für die Resorption und die Verarbeitung unerlässlich sind. Vitamine gibt es 13, Sekundären Pflanzenstoffe gibt es etwa 70.000.
Die modernen Industrienationen haben inzwischen einzigartige Versorgungslage aufgebaut. Viele Produkte sind überall in immer gleicher Qualität verfügbar. Die Produkte sind haltbar und für das Auge schön anzusehen.
Die bekannten Nachteile vieler Produkte, die diese ausgezeichnete Versorgungslage mit sich bringt, sind unter dem Begriff "Denaturierung" zusammengefasst. Dazu gehören:Moderne Zuchtmethoden orientieren sich an der Optik, weniger an den InhaltenModerne Anbaumethoden sind verbunden mit einem notwendigen Einsatz an Herbiziden und Pestiziden; insbesondere in südlichen Ländern sind hierbei Mittel im Einsatz, die in Deutschland schon seit Jahrzehnten verboten sind.Lange Transportwege erfordern eine frühzeitige Ernte der (unreifen) Früchte.Säfte und Konserven: Erhitzung über 80°C (Verlust von Vitalstoffen und Enzymen)Zugabe von Nahrungsmittelzusatzstoffen (Geschmacksverstärker, Emulgatoren, Stabilisatoren, Farben)
Fazit: man kann sich fast nicht mehr natürlich ernähren, selbst wenn man es will.
Aber auch hier gibt es eine interessante Beobachtung:
Jeder Mensch weiß, dass Obst und Gemüse gesund ist. Manche kennen sogar die "5 am Tag"-Kampagne. Aber obwohl es fast jeder weiß, schafft es kaum ein Mensch, sich dementsprechend zu ernähren.
"Keine Zeit", "zu aufwändig", "zu teuer", "da ist doch eh' nix mehr drin" u.ä. sind die Antworten.
Sie als Arzt wissen um die Bedeutung der Ernährung für die Gesundheit, immerhin gaben die Krankenkassen 2005 über 90.000.000.000,00€ für ernährungsbedingte Krankheiten aus.
Was liegt näher, den Therapieplan des Patienten um den Punkt Ernährung zu erweitern? Verschreiben Sie Obst und Gemüse, fünf Portionen jeden Tag.
Denjenigen, die diese Maßnahme nicht umsetzen können, bieten Sie Juice plus an. Juice Plus ist eine Nahrungsergänzung rein aus Obst und Gemüse und hat uns aus folgenden Gründen überzeugt.Anbau in den industriearmen Weiten der USAAnbau von alten vitalstoffreichen SortenGeringer Einsatz von Herbiziden und PestizidenErnte bei VollreifeSofortige KühlungWaschung und Kontrolle des WaschwassersVerarbeitung erst nachdem das Waschwasser frei von allen Giften istVersaftung innerhalb von 24 StundenTrocknung bei max. 34°C, d.h. alle Enzyme bleiben erhalten
Juice Plus ist wirklich das Beste nach Obst und Gemüse.
Ebenfalls vorteilhaft ist der Vertriebsweg:Der Patient schliesst einen Hauslieferservice (HLS) direkt mit dem Vertreiber NSA AG in Basel ab.NSA kümmert sich um die Bezahlung, Lieferung, Verwaltung und Provisionszahlung an SieSie haben keine Lagerhaltung, keine Investitionskosten, keine MindestabnahmemengenSie können sich sogar "Filialen" in der ganzen Welt aufbauen, um deren Verwaltung sich ebenfalls NSA kümmert.Der HLS ist ein Abo, das den Kunden so lange mit Viermonatspaketen zum Vorzugspreis beliefert, bis er kündigt (jederzeit möglich) oder er es nicht mehr braucht. "Herr Doktor, wie lange muss ich die Kapseln denn nehmen?" – " Wie lange wollen Sie sich denn die Zähne putzen?"
Juice Plus ist Therapie und selbstverständlich auch Prophylaxe. Der Patient / Kunde kann davon profitieren, er muss nicht. Eine Monatspackung kostet beim Vertragshändler 55,00 €, im HLS nur noch 49,50€. Der Kunde spart also Geld.
Es gibt Menschen, die finden 50,00€ pro Monat viel Geld. Für die Gesundheit ist es anscheinend viel Geld. Für die Krankheit ist es ganz normal, dass man 100,00€ pro Monat ausgibt, z.B. ein Raucher, der ein Päckchen pro Tag raucht... Ganz normal.
Mehr Informationen zu Juice Plus, Studien und Produkten
Eine der Hauptursachen der Zivilisationskrankheiten, den oxidativen Stress, kann man unter dem Dunkelfeldmikroskop hervorragend sichtbar machen. Oxidativer Stress tut nicht weh - aber schädigt nachhaltig! Eine der Hauptursachen der Zivilisationskrankheiten, den oxidativen Stress, kann man unter dem Dunkelfeldmikroskop hervorragend sichtbar machen. Oxidativer Stress tut nicht weh - aber schädigt nachhaltig!
ProEmsan - eine weitere sinnvolle Ergänzung
Das Thema Darmsanierung gewinnt immer mehr an Bedeutung. Eine gestörte Darmflora wirkt sich auf Resorption und Verarbeitung im Darm sowie den Darm an sich aus: Meteorismus, Obstipation, M.Crohn und Colitis ulcerosa sind Krankheitsbilder, die darin sicherlich auch eine Ursache haben könnten. Deshalb empfiehlt es sich - insbesondere bei chronisch Kranken – den Patienten eine Darmsanierung mit effektiven Mikroorganismen, die die Darmflora wieder in sein natürliches Gleichgewicht bringen, anzubieten.
Die Produkte sind rein natürlich und schadstofffrei.
Der Vertriebsweg ist ähnlich: der Patient bestellt bei Tisso, die Provision geht direkt an Sie.
_____________________________________________________________
Ansprechpartner:
Andreas Volkmann
Tel. 07633-933193
volkmann@igel-für-ärzte.de
|